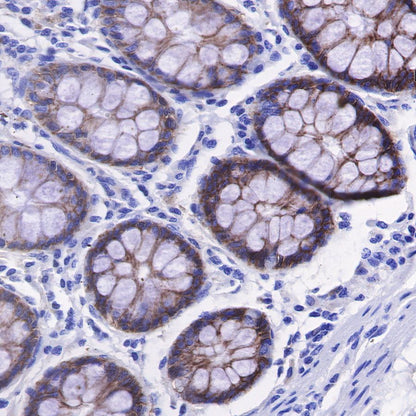
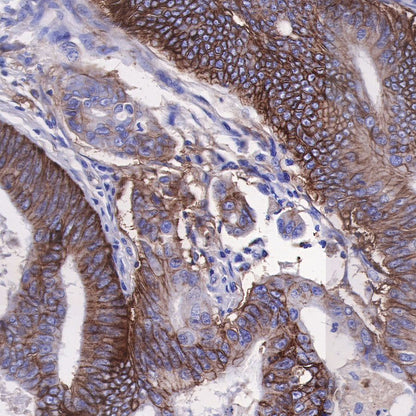

Product Specification
| Host |
Rabbit |
| Antigen |
CD49B / INTEGRIN ALPHA 2 |
| Synonyms |
CD49 antigen-like family member B, Collagen receptor, GPIa, VLA-2 subunit alpha, ITGA2 |
| Immunogen |
Synthetic Peptide |
| Location |
Membrane |
| Accession |
P17301 |
| Clone Number |
SDT-399-52 |
| Antibody Type |
Recombinant mAb |
| Application |
WB, IHC-P |
| Reactivity |
Hu |
| Purification |
Protein A |
| Concentration |
0.5 mg/ml |
| Tag |
N/A |
| Physical Appearance |
Liquid |
| Storage Buffer |
PBS, 40% Glycerol, 0.05% BSA, 0.03% Proclin 300 |
| Stability & Storage |
12 months from date of receipt / reconstitution, -20 °C as supplied |
Dilution
| application |
dilution |
species |
| WB |
1:1000 |
|
| IHC-P |
1:500 |
|
Background
Integrin alpha 2, also known as VLA-2, GPIa-IIa, CD49b, was first identified as an extracellular matrix receptor for collagens and/or laminins. It is now recognized that the Integrin alpha 2 serves as a receptor for many matrix and nonmatrix molecules. Extensive analyses have clearly elucidated the α2 I domain structural motifs required for ligand binding, and also defined distinct conformations that lead to inactive, partially active or highly active ligand binding. The mechanisms by which the Integrin alpha 2 plays a critical role in platelet function and homeostasis have been carefully defined via in vitro and in vivo experiments. Genetic and epidemiologic studies have confirmed human physiology and disease states mediated by this receptor in immunity, cancer, and development [PMID: 25023166].